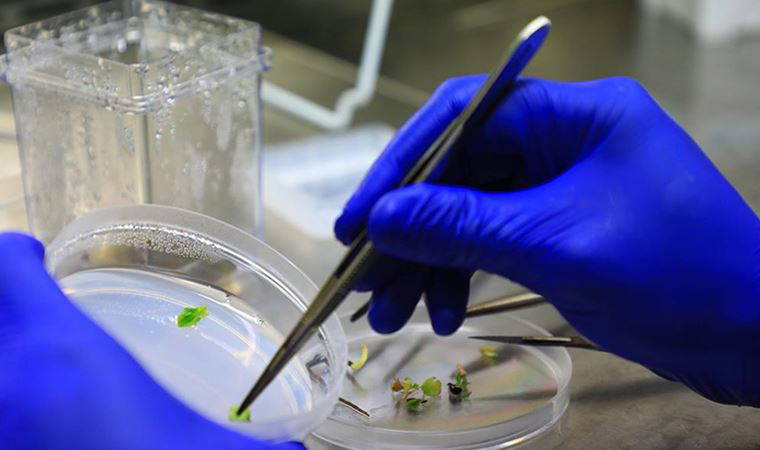
Gökova susamı dondurularak gelecek nesillere aktarılıyor

Muğla Büyükşehir Belediyesinin "Yerel Tohum Ulusal Güç" sloganıyla kurduğu Tıbbi Aromatik Bitkiler ve Yerel Tohum Merkezi, ata tohumlarının toplanmasında kullanılıyor. Tohumlar, özel laboratuvarda donduruluyor.
Özellikle Muğla simidi, tahin ve helva yapımında kullanılan Gökova susamı türünün korunması için çaba gösteriliyor.
Gökova susamının korunması ve gelecek nesillere aktarılması için kitapçık hazırlandı. Kitapçıkta Gökova susamının özellikleri ve saklama teknikleri anlatıldı.